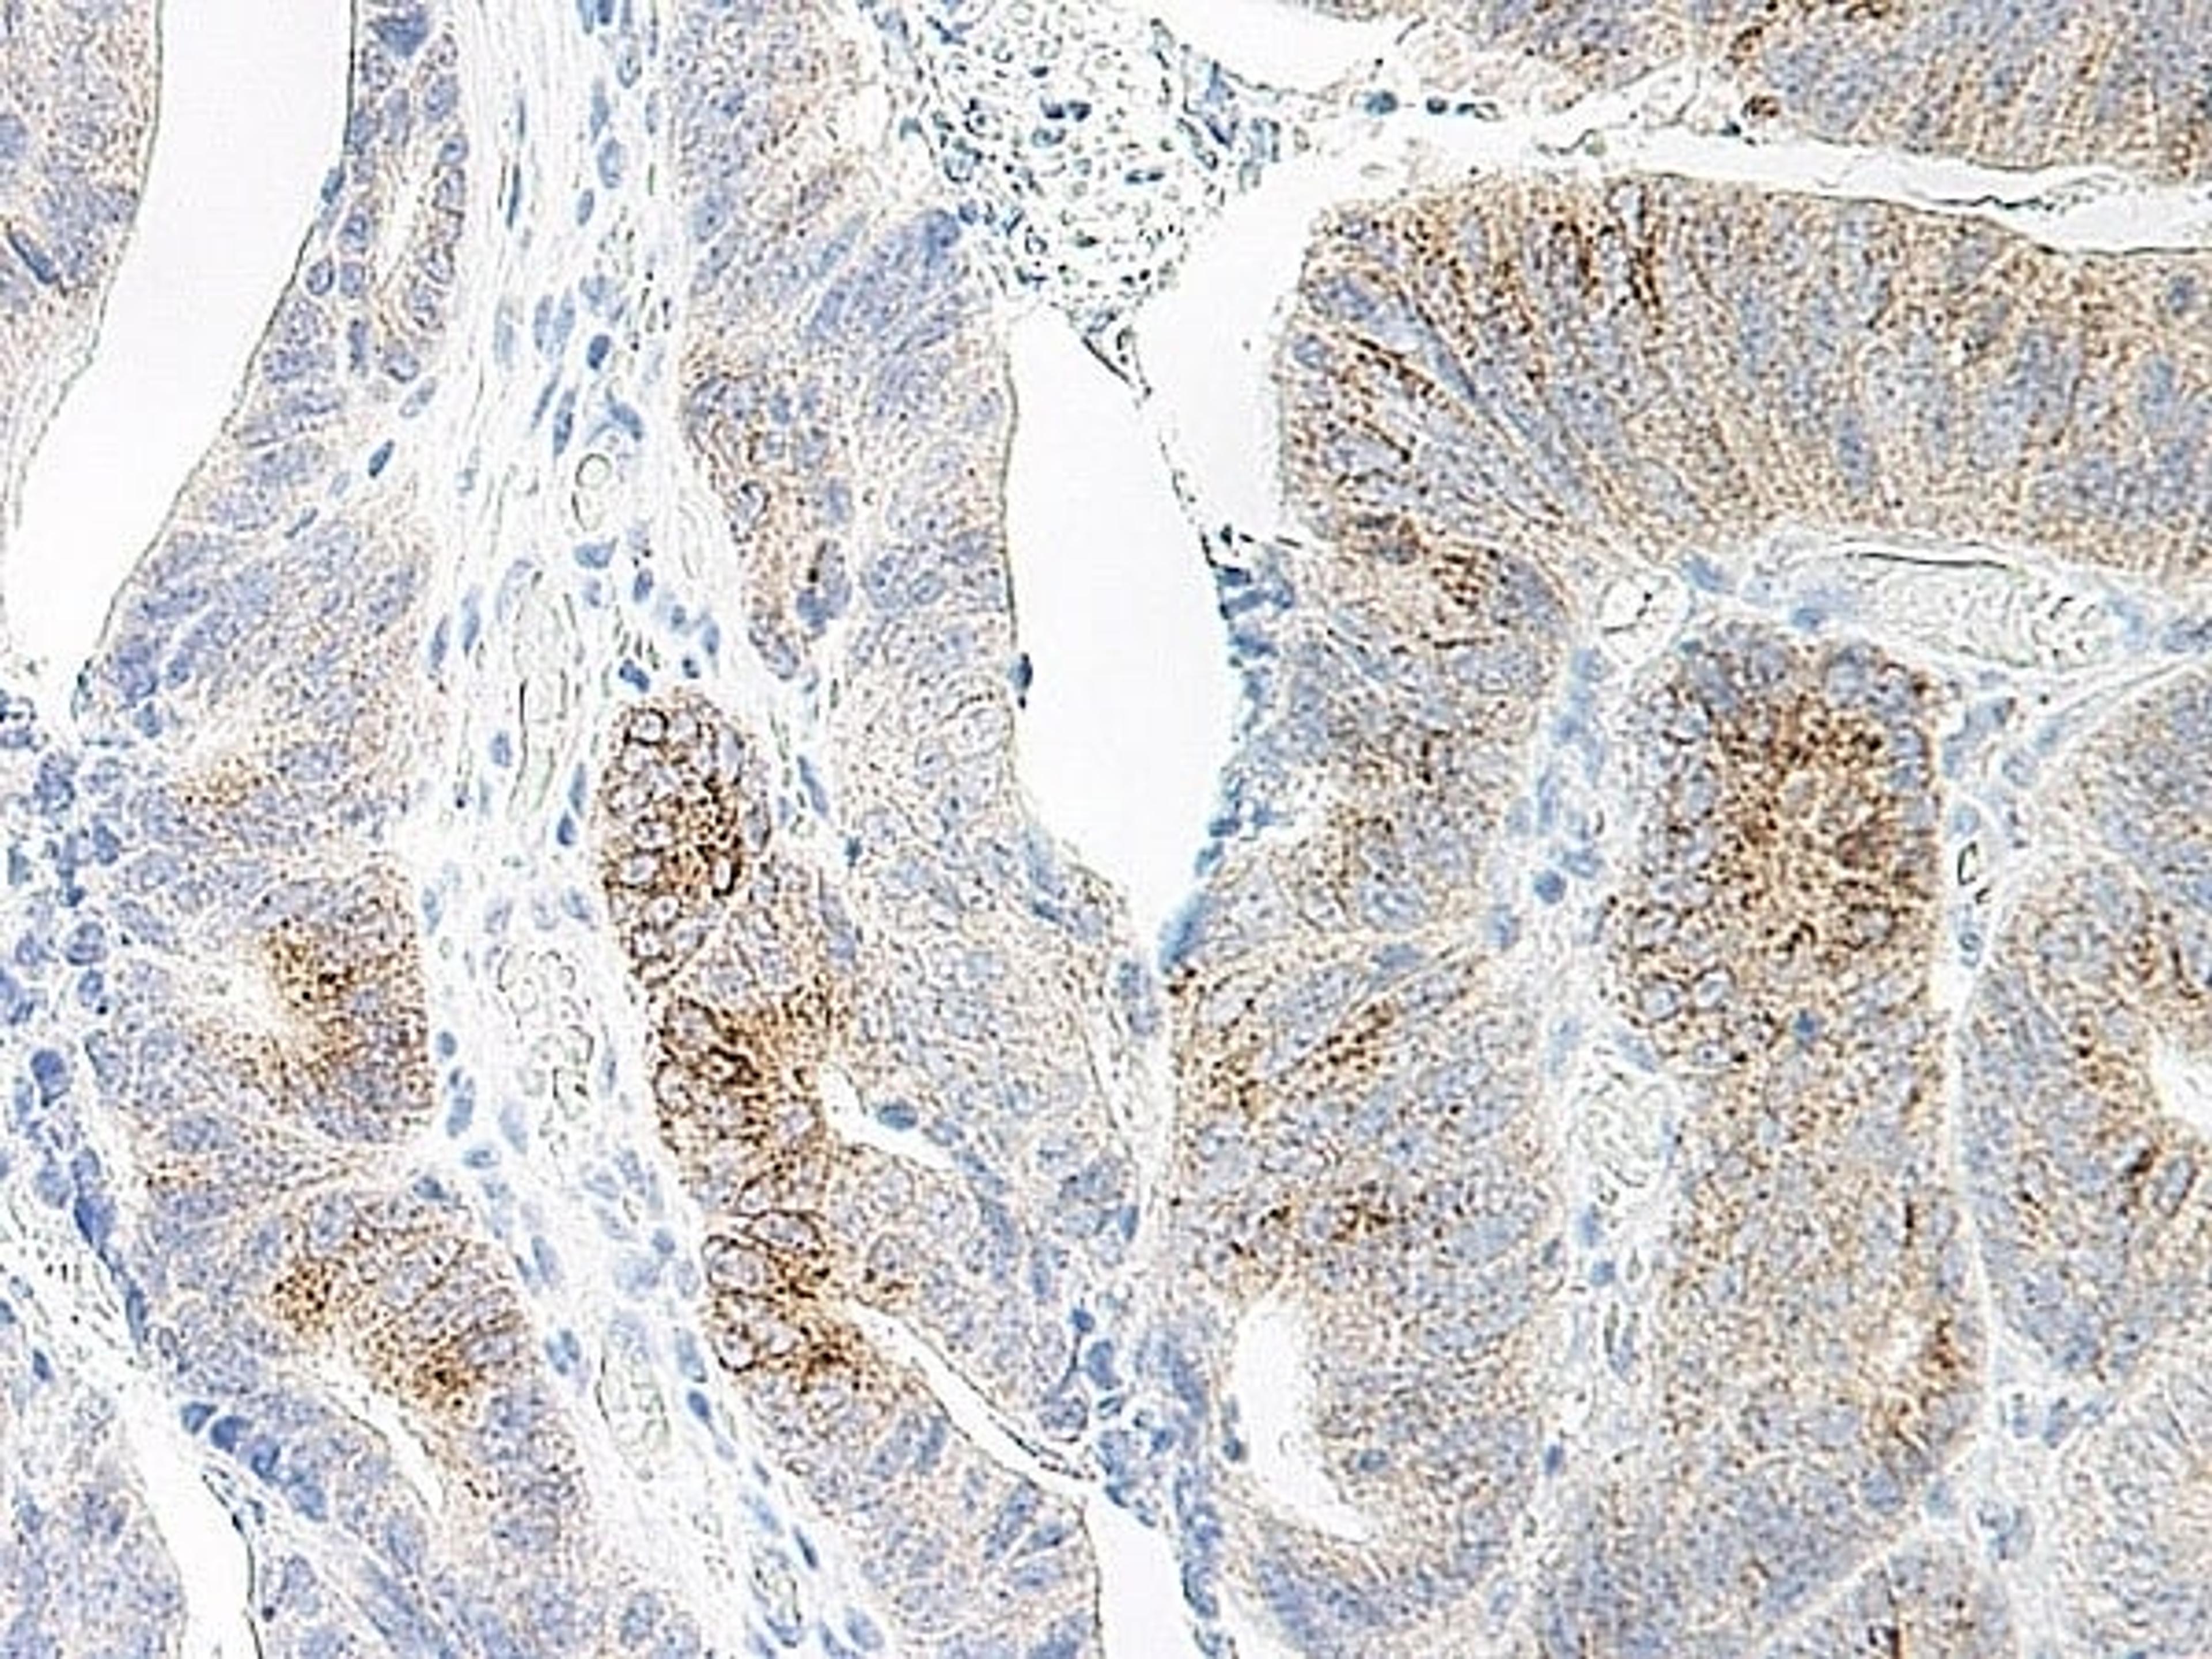

Antibodies
25
Selected Filters:
FLT3 LIGAND
- Manufacturer
- Bio-Rad
- Catalog Number
- AHP770
- Host
- Rabbit
MIP-3 ALPHA
- Manufacturer
- Bio-Rad
- Catalog Number
- AHP788
- Host
- Rabbit
MIP-3 BETA
- Manufacturer
- Bio-Rad
- Catalog Number
- AHP789
- Host
- Rabbit
MIP-3 BETA
- Manufacturer
- Bio-Rad
- Catalog Number
- AHP789B
- Host
- Rabbit
SDF-1 ALPHA
- Manufacturer
- Bio-Rad
- Catalog Number
- AHP794
- Host
- Rabbit